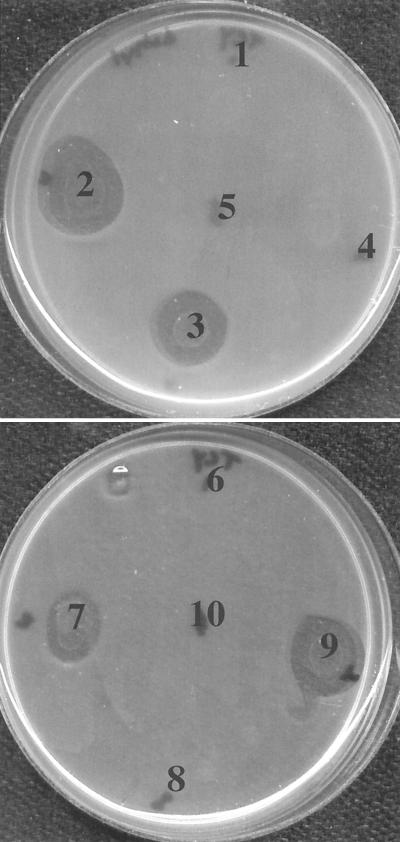
FIG. 2.

Abstract
When ruminal bacteria from a cow fed hay were serially diluted into an anaerobic medium that had only peptides and amino acids as energy sources, little growth or ammonia production was detected at dilutions greater than 10−6. The 10−8 and 10−9 dilutions contained bacteria that fermented carbohydrates, and some of these bacteria inhibited Clostridium sticklandii SR, an obligate amino acid-fermenting bacterium. Phylogenetic analysis indicated that the most active isolate (JL5) was closely related to Butyrivibrio fibrisolvens B835. Strain JL5 inhibited B. fibrisolvens 49 and a variety of other gram-positive organisms, but it had little effect on most gram-negative ruminal bacteria. Strain JL5 did not produce a bacteriocin-like inhibitory substance (BLIS) until it reached the late log or stationary phase. The JL5 BLIS did not cause the lysis of B. fibrisolvens 49, but the intracellular potassium level, the ATP level, the electrical potential, and the viability decreased rapidly. The JL5 BLIS also caused marked decreases in the viability and cellular potassium level of C. sticklandii SR. The membrane potential and intracellular ATP level also declined. The BLIS was degraded very slowly by pronase E, but it could be precipitated with 60% ammonium sulfate and dialyzed (3,500-Da cutoff). The BLIS could be separated from other peptides by polyacrylamide gel electrophoresis, and C. sticklandii SR overlays indicated that the molecular size of this compound was approximately 3,600 Da. Based on these results, it appeared that the JL5 BLIS was a pore-forming peptide. Because carbohydrate-fermenting ruminal bacteria could inhibit the growth of obligate amino acid-fermenting bacteria, BLIS may play a role in regulating ammonia production in vivo.
Some carbohydrate-fermenting ruminal bacteria can deaminate amino acids (3), but these species cannot explain the ammonia production of mixed ruminal bacteria (24). In the 1980s, obligate amino acid-fermenting bacteria (Clostridium aminophilum F, Clostridium sticklandii SR, and Peptostreptococcus anaerobius C) with 20-fold-higher rates of ammonia production were isolated (6, 24). 16S rRNA probes indicated that C. aminophilum F, C. sticklandii SR, and P. anaerobius C accounted for 3% of the total RNA (17), but serial dilutions indicated that the concentrations of these bacteria were ≤106 viable cells/ml when the total ruminal count was 109 viable cells/ml (30).
Attwood et al. (1) isolated two peptostreptococci from wild and domestic ruminants that had high specific activities for ammonia production, but only one of these organisms was closely related to P. anaerobius C. They also isolated an ammonia-producing fusobacterium and a eubacterium, but they did not isolate C. aminophilum or C. sticklandii. The peptostreptococci, fusobacterium, and eubacterium were obtained from 10−8 and 10−9 dilutions of ruminal fluid and grew well in liquid medium. However, several other isolates could not be transferred to broth or grew poorly.
In vitro experiments indicated that C. aminophilum F, C. sticklandii SR, and P. anaerobius C could be inhibited by the bacteriocin nisin, but the impact of naturally occurring ruminal bacteriocins was not examined (4). Some carbohydrate-fermenting ruminal bacteria produce bacteriocins (13, 15, 16, 29), and bacteriocins appear to play a role in fiber digestion (12, 22, 23) and fungal growth (9). In this study we tried to (i) examine the effect of other ruminal bacteria on obligate amino acid-fermenting bacteria, (ii) characterize a potentially inhibitory compound(s), and (iii) determine the mode of inhibition.
MATERIALS AND METHODS
Pure cultures.
C. sticklandii SR, P. anaerobius C, C. aminophilum F, Streptococcus bovis JB1, Ruminococcus albus B199, Fibrobacter succinogenes S85, Selenomonas ruminantium HD-4, and Megasphaera elsdenii B159 were obtained from our culture collection. Butyrivibrio fibrisolvens 49, OB156, B835, and NOR37 were obtained from M. A. Cotta, USDA Agricultural Research Service (Peoria, Ill.). Ruminococcus flavefaciens FD-1 was obtained from T. May, New Mexico State University (Las Cruces, N.M.). B. fibrisolvens AR10, AR27, OB248, and OB236 were obtained from R. J. Forster, Lethbridge Research Centre (Lethbridge, Alberta, Canada). Eubacterium sp. strain C2, Peptostreptococcus sp. strain D1, Peptostreptococcus sp. strain S1, and Fusobacterium sp. strain D4 were obtained from G. T. Attwood, AgResearch (Palmerston North, New Zealand).
Growth.
All cultures were grown anaerobically at 39°C. Basal medium consisted of (per liter) 292 mg of K2HPO4 · 3H2O, 240 mg of KH2PO4, 480 mg of (NH4)SO4, 480 mg of NaCl, 100 mg of MgSO4 · 7H2O, 64 mg of CaCl2 · 2H2O, 500 mg of yeast extract (Difco Laboratories, Detroit, Mich.), 600 mg of cysteine · HCl, 1.0 g of Trypticase (BBL Microbiology Systems, Cockeysville, Md.), 4 g of Na2CO3, and fatty acids (7). Many of the butyrivibrios grew poorly in basal medium, and BV medium contained additional Trypticase (10 mg/ml), yeast extract (2.5 mg/ml), acetate (20 mM), branched-chain volatile fatty acids (1 mmol of isobutyrate per ml, 1 mmol of isovalerate per ml, and 1 mmol of 2-methylbutyrate per ml), hemin (1 μg/ml), vitamins, and microminerals (7). Carbohydrate-fermenting bacteria were given either glucose or cellobiose (4 mg/ml) as an energy source. Obligate amino acid-fermenting bacteria were grown in OAA medium. OAA medium was basal medium that contained additional Trypticase and Casamino Acids (Difco Laboratories) (15 mg/ml each) as energy sources.
Serial dilutions of ruminal fluid.
Ruminal fluid was obtained from a 600-kg ruminally fistulated (diameter, 11 cm) cow fed 100% timothy hay (14% crude protein, 40% neutral detergent fiber). Surgical procedures were approved by the Cornell Institutional Animal Care and Use Committee (protocol 95-1-00). Ruminal contents were squeezed through two layers of cheesecloth, placed in Erlenmeyer flasks at 39°C, and left undisturbed for 30 min. Mixed ruminal bacteria from the center of each flask were serially diluted (10-fold increments) into tubes (18 by 150 mm; Bellco Glass, Vineland, N.J.) containing OAA medium and incubated at 39°C for 72 h. Growth was estimated from increases in the optical density at 600 nm (1-cm cuvette) determined with a Gilford 260 spectrophotometer, and the ammonia content was determined by the colorimetric method of Chaney and Marbach (5).
Isolation of BLIS-producing ruminal bacteria.
The 10−9 and 10−8 dilutions of ruminal fluid (see above) were streaked with an inoculating needle onto BV medium supplemented with glucose (4 mg/ml) and incubated at 39°C for 48 h. The plates were then overlaid with soft agar (0.7%, wt/vol) containing 106 cells of C. sticklandii SR (total volume, 6 ml). The agar overlays were incubated overnight at 39°C and examined for zones of clearing. Colonies that produced a zone of clearing were designated bacteriocin-like inhibitory substance (BLIS)-producing bacteria.
BLIS activity in ruminal fluid and culture supernatants.
Ruminal fluid was centrifuged three times (14,500 × g, 20 min, 4°C), and the cell-free supernatant was filtered (0.45-μm-pore-size MF membrane filter; Millipore, Bedford, Mass.). The filtrate was then refiltered to eliminate residual contamination (0.22-μm MF membrane filter; Whatman International Ltd., Kent, United Kingdom). Cell-free supernatants of carbohydrate-fermenting bacteria were sterile-filtered in a similar manner. Target bacteria were serially diluted (10-fold increments) into sterile-filtered ruminal fluid or culture supernatants that had been supplemented with yeast extract (1 mg/ml) and either glucose (4 mg/ml) or Trypticase and Casamino Acids (15 mg/ml each). The serial dilutions were prepared in 96-well plates (Corning Inc., Corning, N.Y.) inside an anaerobic chamber (Coy Laboratory Products, Inc., Ann Arbor, Mich.). The serial dilutions were incubated at 39°C for at least 72 h, and the growth in each dilution was determined based on increases in optical density.
Effect of JL5 BLIS on ammonia production by mixed ruminal bacteria.
Mixed ruminal bacteria from a cow fed hay were centrifuged (1,000 × g, 10 min, 22°C) to remove feed particles and protozoans. The ruminal supernatant was centrifuged a second time to harvest mixed ruminal bacteria (6,000 × g, 20 min, 22°C). The mixed ruminal bacteria were washed with buffer lacking ammonia, and the cells were resuspended in sterile-filtered B. fibrisolvens 49 or JL5 supernatant. Cell suspensions (2.0 optical density units) were incubated at 39°C for 4 h, and ammonia contents were determined by the method of Chaney and Marbach (5). The protein contents of washed cells were determined by the method of Lowry et al. (19).
Phylogenetic analysis.
Chromosomal DNA was purified from strain JL5 with a FastDNA spin kit (Bio 101, Vista, Calif.). Chromosomal DNA (100 ng) was mixed with primers (40 pmol of 27F and 1492R [18]), and the 16S ribosomal DNA (rDNA) region was amplified (Sprint thermocycler; Hybaid Ltd., Middlesex, United Kingdom) by using Ready-to-Go PCR beads (Amersham Pharmacia Biotech, Piscataway, N.J.). The conditions used were as follows: (i) denaturation at 94°C for 5 min; (ii) 35 cycles of 94°C for 0.5 min, 55°C for 1 min, and 72°C for 1 min; and (iii) a final extension step at 72°C for 5 min. PCR products were cloned by using the pGEM-Vector system (Promega, Madison, Wis.), and clones were sequenced six times at the Cornell Biotechnology Center. Two primers (M13 and T7) were based on the plasmid cloning site, and four primers (926F, 787R, 907R, and 530F) were based on internal conserved regions (18). Sequences were assembled and edited by using the SeqMan component of the Lasergene package (DNASTAR Inc., Madison, Wis.), and they were aligned with known Butyrivibrio 16S rRNA sequences by using ClustalX (27). Similarities were computed by using Similarity Matrix (version 1.1) of the Ribosomal Database Project (21). Sequences were checked for chimeras by using the Chimera Check service (version 2.7) of the Ribosomal Database Project (21). Phylogenetic trees were constructed by using the neighbor-joining method included in the PHYLIP software (11).
Intracellular potassium.
Exponentially growing cultures (10 ml, approximately 200 μg of protein/ml) of C. sticklandii SR and B. fibrisolvens 49 were harvested by centrifugation (4,000 × g, 15 min, 22°C), and the cell pellets were resuspended anaerobically in B. fibrisolvens JL5 or 49 supernatant (10 ml) that had been supplemented with glucose (4 mg/ml). Samples (1 ml) were centrifuged (13,000 × g, 5 min, 22°C) through 0.3 ml of a mixture of Dow Corning 550 and 556 silicon oils (50:50 ratio for C. sticklandii SR and 70:30 ratio for B. fibrisolvens 49; Dow-Corning Corp., Midland, Mich.). The microcentrifuge tubes were frozen (−20°C), and the bottoms of the tubes containing the cell pellets were removed with a pair of dog nail clippers. The cell pellets were digested (22°C, 24 h, 3 N HNO3), and the insoluble cell debris was removed by centrifugation (13,000 × g, 5 min, 22°C). Potassium contents were determined with a flame photometer (Cole-Parmer 2655-00 digital flame analyzer; Cole-Parmer Instrument Co., Chicago, Ill.). The potassium contents of cell suspensions treated with nigericin and valinomycin (5 μM each) were subtracted to determine free intracellular potassium contents.
Membrane potential.
Exponentially growing cultures (10 ml, approximately 200 μg of protein/ml) of C. sticklandii SR and B. fibrisolvens 49 were harvested by centrifugation (4,000 × g, 15 min, 22°C), and the cell pellets were resuspended anaerobically in B. fibrisolvens JL5 or 49 supernatant (10 ml) that had been supplemented with glucose (4 mg/ml). Samples (2 ml) were then incubated anaerobically with [3H]tetraphenylphosphonium bromide ([3H]TPP+) (0.25 μCi, 34 μCi/μmol) for 10 min at 39°C. Cells were harvested by silicon oil centrifugation (see above), and the cell pellets were dissolved in scintillation fluid overnight prior to scintillation counting. The electrical potential (ΔΨ) was determined by determining the uptake [3H]TPP+ according to the Nernst relationship. Nonspecific binding of [3H]TPP+ to cells was estimated by examining cells that were treated with valinomycin and nigericin (5 μM each). The intracellular volume of C. sticklandii SR is 2.4 μl/mg of protein (28). The intracellular volume of B. fibrisolvens 49 (3.1 μl/mg of protein) was estimated from the difference between 3H2O uptake and [14C]citrate uptake.
Intracellular ATP.
Exponentially growing cultures (10 ml, approximately 200 μg of protein/ml) of C. sticklandii SR and B. fibrisolvens 49 were harvested by centrifugation (4,000 × g, 15 min, 22°C), and the cell pellets were resuspended anaerobically in B. fibrisolvens JL5 or 49 supernatant (10 ml) that had been supplemented with glucose (4 mg/ml). Samples (1 ml) were transferred to microcentrifuge tubes in which 0.4 ml of the 70:30 silicon oil mixture was layered on top of 100 μl of 14% perchloric acid-9 mM EDTA. After centrifugation (13,000 × g, 5 min), the supernatant and silicon oil layers were removed by suction. The cell pellet and perchloric acid were mixed and left on ice for 20 min. The extracts were neutralized with 100 μl of 0.8 M KOH-0.3 M K2CO3 and frozen. The neutralized extracts were centrifuged and refrozen to remove KClO4. The neutralized extracts were diluted 50-fold with 40 mM Tris-SO4 containing 2 mM EDTA, 10 mM MgCl2, and 0.1% bovine serum albumin (pH 7.75). Luciferase reactions were initiated by adding 100 μl of a purified luciferine-luciferase mixture to 100 μl of diluted extract according to the supplier's recommendations (Sigma Chemical Co., St. Louis, Mo.). Light output was immediately measured with a luminometer (model 1250; LKB Instruments, Inc., Gaithersburg, Md.) by using ATP as the standard (20). All samples were corrected for extracellular adenine nucleotides.
Partial purification of BLIS.
B. fibrisolvens JL5 was grown in 1 liter of BV medium containing 4 mg of glucose per ml but lacking resazurin, and cells were harvested by centrifugation (20 min, 8,200 × g, 4°C). The cell-free supernatant was treated at 4°C for 1 h in stepwise fashion with increasing amounts of (NH4)2SO4, and precipitated material was harvested by centrifugation (30 min, 8,200 × g, 4°C). The 40 to 60% (NH4)2SO4 precipitate was resuspended in 6.6 ml of K2HPO4 buffer (100 mM, pH 6.0) and placed in a dialysis bag (3,500-Da cutoff; Pierce Chemical Co., Rockford, Ill.). The dialyzed fraction was digested with proteinase K (12 U/ml) and separated by Tris-Tricine-sodium dodecyl sulfate-polyacrylamide gel electrophoresis (PAGE) (15% acrylamide) (2). One half of the gel was silver stained (Bio-Rad Laboratories, Richmond, Calif.). The other half was fixed with 10% acetate-20% isopropanol for 30 min. The gel was washed with MilliQ water for 1 h, covered with moist Kimwipes (Kimberly-Clark, Mississauga, Ontario, Canada), placed in a glove box, and allowed to equilibrate under anaerobic conditions. After 3 h, the gel was overlaid with 6 ml of soft agar containing 106 cells of C. sticklandii SR.
Fermentation products.
Fermentation acids were analyzed by high-pressure liquid chromatography with a Beckman 110B chromatograph equipped with an Altex 156 refractive index detector and a Bio-Rad HPX-87H organic acid column. The sample size was 20 μl, the eluant was 0.013 N H2SO4, the flow rate was 0.5 ml/min, and the column temperature was 50°C.
Statistics.
All measurements were performed in duplicate, and the experimental variation was generally less than 10%. When the coefficient of variation was greater than 10% and the standard deviations were large, statistical significance was estimated by paired t tests (P < 0.05).
Chemicals and reagents.
Pronase E (type XIV), trypsin (bovine pancreas), chymotrypsin (bovine pancreas), ultra-low range molecular weight marker, nigericin, and valinomycin were obtained from Sigma, and proteinase K (fungal) was obtained from GibcoBRL (Rockville, Md.).
Nucleotide sequence accession number.
The 16S rDNA sequence of B. fibrisolvens JL5 has been deposited in the GenBank database under accession no. AY029616.
RESULTS
Inhibition of obligate amino acid-fermenting bacteria.
C. sticklandii SR, C. aminophilum F, and P. anaerobius C grew well in OAA medium that contained Trypticase and Casamino Acids as energy sources, and the highest serial dilutions showing growth indicated that stationary-phase cultures contained approximately 108 viable cells/ml (data not shown). However, if the same stationary-phase cultures were serially diluted into sterile-filtered ruminal fluid that was supplemented with the same amounts of Trypticase and Casamino Acids, there was a sharp transition from growth to nongrowth, increases in optical density were never detected at dilutions greater than 10−3, and the viability was at least 105-fold lower. Treatment of the ruminal fluid with either proteinase K (12 U/ml) or pronase E (4 U/ml) for 2 h did not increase the viability of the cultures (data not shown).
Mixed ruminal bacteria.
When ruminal fluid from a cow fed hay was serially diluted into basal medium supplemented with glucose (4 mg/ml), the viable cell count was ≥109 cells per ml (data not shown). When the same ruminal fluid was serially diluted into basal medium supplemented with Trypticase (15 mg/ml), the optical densities were more than 1.5 and the ammonia concentrations were as high as 100 mM after 72 h, but only if the dilutions were less than 10−5 (Fig. 1). The high-dilution tubes (10−8 or 10−9) had very low optical densities, and obligate amino acid-fermenting bacteria could not be isolated.
FIG. 1.
Growth (•) and ammonia production (○) of mixed ruminal bacteria that were serially diluted (10-fold increments) into basal medium containing Trypticase and Casamino Acids (15 mg/ml each). The tubes were incubated for 72 h.
Bacterial antagonism.
The 10−9 dilution of ruminal fluid (Fig. 1) did not contain viable obligate amino acid-fermenting bacteria, but it contained two different types of glucose-utilizing bacteria (a total of 10 selenomonad and vibrio strains) that could be easily isolated. All of the vibrios (four isolates) inhibited the growth of C. sticklandii SR (Fig. 2) in agar overlays and appeared to produce a BLIS, but zones of clearing were not observed with the selenomonads (six isolates). BLIS-producing bacteria were obtained from the 10−8 and 10−9 dilutions of ruminal fluid on several occasions. The vibrio strain that produced the largest zone of clearing was designated JL5. Strain JL5 grew slowly in OAA medium even if glucose was added, but it grew rapidly (growth rate, approximately 0.4 h−1) in BV medium that contained additional carbon sources (yeast extract, glucose, and acetate).
FIG. 2.
Effect of carbohydrate-fermenting bacteria isolated from high dilutions of ruminal fluid (10−9) on the growth of C. sticklandii SR in agar overlays. Isolates in areas 2, 3, 7, and 9 were vibrios. Isolates in areas 1, 4, 5, 6, 8, and 10 were selenomonads. The isolate in area 2 was designated JL5.
Identification of JL5.
Strain JL5 utilized a variety of hexoses (glucose, mannose, rhamnose, galactose, fructose, rhamnose), pentoses (arabinose, xylose, xylan), and disaccharides (cellobiose, maltose, lactose, sucrose, melibiose, trehalose) and a trisaccharide (raffinose) for growth, but it grew poorly on starch and cellulose. No growth was observed if glycerol, mannitol, melizitose, ribose, or sorbitol was provided. Strain JL5 stained gram positive, produced large amounts of butyrate from glucose, and was strongly inhibited by 5 μM monensin (data not shown). 16S rDNA sequencing indicated that JL5 was closely related (99.9% similarity) to B. fibrisolvens B835 (Fig. 3).
FIG. 3.
Phylogenetic relationship of isolate JL5 to other butyrivibrios and other ruminal bacteria. (The genera are Megasphaera, Peptostreptococcus, Clostridium, Butyrivibrio, and Acetitomaculum.) Sequences based on 16S rDNA were aligned with ClustalX, and the tree was constructed by the neighbor-joining method included in PHYLIP 3.1. Scale bar = 10% difference in nucleotide sequence.
Spectrum of activity.
Agar overlays indicated that JL5 strongly inhibited some butyrivibrios and ruminococci, but JL5 had little if any effect on S. bovis JB1 or B. fibrisolvens AR27, OB236, or NOR37 (Table 1). Strain JL5 did not inhibit most of the gram-negative carbohydrate-fermenting bacteria tested, but a zone of clearing was observed with Prevotella bryantii B14. Strain JL5 inhibited all of the obligate amino acid-fermenting bacteria tested. When the target bacteria were serially diluted into sterile-filtered supernatants of B. fibrisolvens JL5, growth was often strongly inhibited. Viability declined as the clearing zone diameter on agar plates increased. Cultures that were serially diluted into sterile-filtered supernatants of B. fibrisolvens 49 (a non-BLIS-producing strain) were not significantly inhibited. When mixed ruminal bacteria from a cow fed hay were harvested by centrifugation and incubated in strain JL5 sterile-filtered BV medium supernatant, the initial rate of ammonia production was 18% lower than the initial rate determined with strain 49 supernatant (data not shown).
TABLE 1.
Effect of B. fibrisolvens JL5 on growth of various ruminal bacteriaa
| Bacterium | Zone of clearingb | Log viable cells/ml
|
|
|---|---|---|---|
| Growth in JL5 supernatant | Growth in 49 supernatant | ||
| Gram-positive, carbohydrate-fermenting bacteria | |||
| B. fibrisolvens JL5 | − | 8.5 ± 0.7 | 9.0 ± 0.0 |
| B. fibrisolvens 49 | +++ | NGc | 9.0 ± 0.0 |
| B. fibrisolvens AR10 | ++ | NG | 8.0 ± 0.7 |
| B. fibrisolvens OB156 | +++ | 0.5 ± 0.7 | 7.5 ± 2.1 |
| B. fibrisolvens OB248 | ++ | 1.0 ± 1.4 | 8.0 ± 1.4 |
| B. fibrisolvens B835 | +++ | 4.5 ± 3.5 | 8.5 ± 0.7 |
| B. fibrisolvens AR27 | − | 9.0 ± 0.0 | 9.0 ± 0.0 |
| B. fibrisolvens OB236 | − | 8.5 ± 0.7 | 9.0 ± 0.0 |
| B. fibrisolvens NOR37 | − | 9.0 ± 0.0 | 8.5 ± 0.7 |
| R. albus B199 | ++++ | NG | 8.0 ± 1.4 |
| R. flavefaciens FD-1 | ++++ | NG | 8.5 ± 0.7 |
| S. bovis JB1 | − | 8.0 ± 0.0 | 8.5 ± 0.7 |
| Gram-negative, carbohydrate-fermenting bacteria | |||
| P. bryantii B14 | + | 5.0 ± 1.0 | 8.0 ± 0.0 |
| F. succinogenes S85 | − | 7.0 ± 1.4 | 8.5 ± 0.7 |
| S. ruminantium HD-4 | − | 8.0 ± 0.0 | 8.0 ± 0.0 |
| M. elsdenii B159 | − | 8.0 ± 0.0 | 8.0 ± 0.0 |
| Gram-positive, obligate amino acid-fermenting bacteria | |||
| C. sticklandii SR | ++++ | NG | 8.5 ± 0.7 |
| Eubacterium sp. strain C2 | +++ | NG | 7.0 ± 0.0 |
| P. anaerobius C | +++ | 0.3 ± 0.6 | 7.7 ± 0.6 |
| Peptostreptococcus sp. strain D1 | ++ | 0.5 ± 0.7 | 7.0 ± 0.0 |
| Peptostreptococcus sp. strain S1 | ++ | 3.0 ± 0.0 | 8.0 ± 0.0 |
| C. aminophilum F | + | 6.0 ± 1.0 | 8.5 ± 0.6 |
| Gram-negative, obligate amino acid-fermenting bacteria | |||
| Fusobacterium sp. strain D4 | + | 6.5 ± 0.7 | 9.0 ± 0.0 |
B. fibrisolvens 49 was used as a control.
The zones of clearing ranged from nonexistent (−) to a diameter of >2.0 cm (++++).
NG, no growth detected.
BLIS production and mode of action.
C. sticklandii SR cultures that were serially diluted into sterile-filtered supernatant from early-log-phase JL5 cultures contained ≥108 viable cells/ml. Inhibitory activity began to appear in the mid-log to late log phase, and by the stationary phase the C. sticklandii SR viability was zero (Fig. 4). When B. fibrisolvens 49 cultures were harvested by centrifugation and resuspended in sterile-filtered B. fibrisolvens 49 culture supernatant containing 4 mg of glucose per ml, the intracellular potassium level and viability did not decrease (Fig. 5a). However, if B. fibrisolvens 49 cells were resuspended in sterile-filtered B. fibrisolvens JL5 culture supernatant supplemented with glucose, the potassium level and viability decreased dramatically. C. sticklandii SR cells also lost potassium and became nonviable if they were resuspended in sterile-filtered B. fibrisolvens JL5 culture supernatant, but the effect was at least fivefold slower (Fig. 5b). B. fibrisolvens 49 and C. sticklandii SR cells that were resuspended in sterile-filtered glucose-supplemented B. fibrisolvens 49 culture supernatant had membrane potentials (ΔΨ) of −113 and −161 mV, respectively, and the intracellular ATP concentrations were 1.9 and 3.6 mM, respectively. When B. fibrisolvens 49 cells were resuspended in sterile-filtered B. fibrisolvens JL5 culture supernatant, the ΔΨ and the ATP concentration were 0 mV and 0.7 mM, respectively, values similar to those observed in the presence of nigericin and valinomycin (5 μM each). Nigericin- and valinomycin-treated C. sticklandii SR cells had very low ΔΨ and ATP values (0 mV and 1.8 mM, respectively), but JL5-treated cells had ΔΨ and ATP values of −131 mV and 2.4 mM, respectively.
FIG. 4.
Growth of B. fibrisolvens JL5 (•), as determined by optical density at 600 nm, and the ability of sterile-filtered JL5 culture supernatant to inhibit C. sticklandii SR (○). Samples of a B. fibrisolvens JL5 culture were removed at various times. C. sticklandii SR was serially diluted into the sterile-filtered supernatants to assess BLIS production.
FIG. 5.
Viability (circles) and free intracellular potassium level (triangles) for B. fibrisolvens 49 (a) and C. sticklandii SR (b). Open symbols, cells that were incubated in BV medium; solid symbols, cells that were incubated in sterile-filtered JL5 culture supernatant.
BLIS characterization and purification.
C. sticklandii SR cultures that were serially diluted into full-strength JL5 supernatant contained ≤100 viable cells (Table 1), and even 10-fold-diluted supernatant caused a 4-log reduction in viability (data not shown). Autoclaved (120°C, 20 min) JL5 supernatant depressed the viability of C. sticklandii SR, but the inhibition was not as great (10-fold-diluted material caused only a 2-log reduction in viability). Undiluted supernatant that was treated with proteinase K (12 U/ml), pronase E (4 U/ml), trypsin (11.3 U/ml), or chymotrypsin (41 U/ml) killed virtually all of the C. sticklandii SR cells, but some decrease in BLIS activity was observed if the culture supernatant was diluted 50-fold and treated with pronase E. Supernatants that were bubbled with O2 retained activity if they were returned to an anaerobic chamber (data not shown).
The BLIS was partially purified by ammonium sulfate precipitation, and activity was detected in the 40 to 60% ammonium sulfate fraction (data not shown). The 40 to 60% ammonium sulfate fraction could be dialyzed (3,500-Da cutoff) with no apparent loss of activity, and the active fraction was separated by Tris-Tricine-PAGE (Fig. 6). When one-half of a gel was overlaid with soft agar containing C. sticklandii SR, the zone of clearing was at a position corresponding to a silver-stained band at approximately 3,600 Da.
FIG. 6.
Tris-Tricine-PAGE of JL5 BLIS. The positions of molecular mass standards (lane Std) are indicated on the left. Lane A, silver-stained 40 to 60% (NH4)2SO4 fraction; lane B, unstained PAGE gel that was overlaid with soft agar containing C. sticklandii SR.
DISCUSSION
Previous work indicated that cattle fed hay had obligate amino acid-fermenting ruminal bacteria (1, 6, 17, 24), and a mathematical model based on kinetic parameters indicated that these bacteria should account for approximately 5% of the total population (25). However, if ruminal fluid from a cow fed the same type of hay was serially diluted into basal medium supplemented with amino acids and peptides, little growth and ammonia production were detected in dilutions of ≥10−6 (Fig. 1). Because addition of sterile ruminal fluid (5%, vol/vol) did not eliminate this fade-out (data not shown), the reduced growth could not be explained by a nutritional deficiency per se.
When previously isolated obligate amino acid-fermenting bacteria were diluted into filter-sterilized ruminal fluid, the numbers of viable cells were very low, and this result indicated that a BLIS might be inhibiting growth. This hypothesis was supported by the isolation of a glucose-utilizing, BLIS-producing butyrivibrio (strain JL5) from the10−9 dilution. 16S rDNA sequencing indicated that JL5 was closely related to B. fibrisolvens B835 (Fig. 3), but B835 did not inhibit C. sticklandii SR or B. fibrisolvens 49. Strain JL5 was a member of the same clade as B. fibrisolvens OB236 and NOR37, and the latter strains inhibit other butyrivibrios (16).
Because dilution series indicated that sterile-filtered JL5 supernatants lost activity if the dilution was more than 50-fold, the inhibition did not appear to be caused by a bacteriophage. Moreover, since sterile-filtered supernatant of B. fibrisolvens 49, an organism that does not produce BLIS (16), had no activity, the inhibition of C. sticklandii SR was not due to organic acids. Strain JL5 inhibited a variety of gram-positive organisms, but it had little effect on S. bovis or some butyrivibrios (Table 1). S. ruminantium and M. elsdenii are closely related to gram-positive bacteria, but they have outer wall layers (26) and they were not inhibited by strain JL5 (Table 1). Some bacteriocin-producing bacteria are resistant to the bacteriocins of closely related bacteria (16). B. fibrisolvens JL5 had no effect on B. fibrisolvens OB236 and NOR37, but it inhibited one bacteriocin-producing butyrivibrio (OB156).
Kalmokoff and Teather (16) found that many butyrivibrios produced BLIS only on agar, and these authors were often unable to demonstrate BLIS production in liquid medium. Strain JL5 released its BLIS into the cell-free supernatant, and the viability of target bacteria in sterile-filtered supernatant declined as the clearing zone diameter on agar plates increased. Most butyrivibriocins can be inactivated by proteolytic digestion (16). The JL5 BLIS was resistant to proteinase K, trypsin, or chymotrypsin, and pronase E was able to inactivate only supernatant that had been diluted 50-fold. Because the spectrum of activity of JL5 against other butyrivibrios was different from that of previously characterized strains (16), it appears that the JL5 BLIS is novel.
Many bacteriocins form pores in the cell membranes of sensitive cells, facilitate the efflux of intracellular ions, and cause ATP depletion (14). However, bacteriocin binding and survival of sensitive cells can be influenced by specific receptors or cell wall characteristics (8, 10). Until now, the mode of action of ruminal butyrivibriocins was not known (16). When B. fibrisolvens 49 was incubated with JL5 supernatant, the intracellular potassium level, the ΔΨ, ATP level, and viability decreased rapidly. Based on these results, it appears that the JL5 BLIS is, indeed, a pore-forming peptide. The JL5 BLIS also caused a decrease in the potassium content and viability of C. sticklandii SR. However, the latter action was much slower, and the decreases in the ΔΨ and the ATP level were not nearly as great. Whether the difference is due to the amount of BLIS bound to C. sticklandii SR is not yet known.
The inhibitory activity of B. fibrisolvens JL5 is consistent with the observation that obligate amino acid-fermenting bacteria could not be isolated from high dilutions of ruminal fluid, and mixed ruminal bacteria that were incubated in strain JL5 culture supernatant produced less ammonia than mixed ruminal bacteria that were incubated in strain 49 supernatant. The BLIS of JL5 caused an 18% decrease in the specific activity of mixed ruminal bacteria, and previous work indicated that the gram-positive antibiotic monensin caused only a 37% decline (30). Based on the latter comparison, BLIS could have a nutritionally significant impact in vivo.
Acknowledgments
J.B.R. is a member of the U.S. Dairy Forage Research Center, Madison, Wis. We thank Hilario Mantovani for his valuable and helpful discussions during this research.
REFERENCES
- 1.Attwood, G. T., A. V. Klieve, D. Ouwerkerk, and B. K. Patel. 1998. Ammonia-hyperproducing bacteria from New Zealand ruminants. Appl. Environ. Microbiol. 64:1794-1804. [DOI] [PMC free article] [PubMed] [Google Scholar]
- 2.Ausubel, F., R. Brent, R. E. Kingston, D. D. Moore, J. G. Seidman, J. A. Smith, and K. Struhl. 1997. Short protocols in molecular biology, 3rd ed. John Wiley & Sons, New York, N.Y.
- 3.Bladen, H. A., M. P. Bryant, and R. N. Doetsch. 1961. A study of bacterial species from the rumen which produce ammonia from protein hydrolysate. Appl. Microbiol. 9:175-180. [DOI] [PMC free article] [PubMed] [Google Scholar]
- 4.Callaway, T. R., A. M. S. Carneiro De Melo, and J. B. Russell. 1997. The effect of nisin and monensin on ruminal fermentations in vitro. Curr. Microbiol. 35:90-96. [DOI] [PubMed] [Google Scholar]
- 5.Chaney, A. L., and E. P. Marbach. 1962. Modified reagents for determination of urea and ammonia. Clin. Chem. 8:130-132. [PubMed] [Google Scholar]
- 6.Chen, G., and J. B. Russell. 1989. More monensin-sensitive, ammonia-producing bacteria from the rumen. Appl. Environ. Microbiol. 55:1052-1057. [DOI] [PMC free article] [PubMed] [Google Scholar]
- 7.Cotta, M. A., and J. B. Russell. 1982. Effect of peptides and amino acids on efficiency of rumen bacterial protein synthesis in continuous culture. J. Dairy Sci. 65:226-234. [Google Scholar]
- 8.Crupper, S. S., A. J. Giles, and J. J. Iandolo. 1997. Purification and characterization of staphylococcin BacR1, a broad-spectrum bacteriocin. Appl. Environ. Microbiol. 63:4185-4190. [DOI] [PMC free article] [PubMed] [Google Scholar]
- 9.Dehority, B. A., and P. A. Tirabasso. 2000. Antibiosis between ruminal bacteria and ruminal fungi. Appl. Environ. Microbiol. 66:2921-2927. [DOI] [PMC free article] [PubMed] [Google Scholar]
- 10.Ennahar, S., T. Sashihara, K. Sonomoto, and A. Ishizaki. 2000. Class IIa bacteriocins: biosynthesis, structure and activity. FEMS Microbiol. Rev. 24:85-106. [DOI] [PubMed] [Google Scholar]
- 11.Felsenstein, J. 1993. PHYLIP (phylogeny inference package), 3.5c ed. Department of Genetics, University of Washington, Seattle.
- 12.Fondevila, M., and B. A. Dehority. 1996. Interactions between Fibrobacter succinogenes, Prevotella ruminicola, and Ruminococcus flavefaciens in the digestion of cellulose from forages. J. Anim. Sci. 74:678-684. [DOI] [PubMed] [Google Scholar]
- 13.Iverson, W. G., and N. F. Mills. 1976. Bacteriocins of Streptococcus bovis. Can. J. Microbiol. 22:1040-1047. [DOI] [PubMed] [Google Scholar]
- 14.Jack, R. W., J. R. Tagg, and B. Ray. 1995. Bacteriocins of gram-positive bacteria. Microbiol. Rev. 59:171-200. [DOI] [PMC free article] [PubMed] [Google Scholar]
- 15.Kalmokoff, M. L., F. Bartlett, and R. M. Teather. 1996. Are ruminal bacteria armed with bacteriocins? J. Dairy Sci. 79:2297-2308. [DOI] [PubMed] [Google Scholar]
- 16.Kalmokoff, M. L., and R. M. Teather. 1997. Isolation and characterization of a bacteriocin (butyrivibriocin AR10) from the ruminal anaerobe Butyrivibrio fibrisolvens AR10: evidence in support of the widespread occurrence of bacteriocin-like activity among ruminal isolates of B. fibrisolvens. Appl. Environ. Microbiol. 63:394-402. [DOI] [PMC free article] [PubMed] [Google Scholar]
- 17.Krause, D. O., and J. B. Russell. 1996. An rRNA approach for assessing the role of obligate amino acid-fermenting bacteria in ruminal amino acid degradation. Appl. Environ. Microbiol. 62:815-821. [DOI] [PMC free article] [PubMed] [Google Scholar]
- 18.Lane, D. J. 1991. 16S/23S rRNA sequencing, p. 115-175. In E. Stackebrandt and M. Goodfellow (ed.), Nucleic acid techniques in bacteria. John Wiley & Sons, New York, N.Y.
- 19.Lowry, O. H., N. J. Rosebrough, A. L. Farr, and R. J. Randall. 1951. Protein measurement with the Folin phenol reagent. J. Biol. Chem. 193:265-275. [PubMed] [Google Scholar]
- 20.Lundin, A., and A. Thore. 1975. Comparison of methods for extraction of bacterial adenine nucleosides determined by firefly assay. Appl. Environ. Microbiol. 30:713-721. [DOI] [PMC free article] [PubMed] [Google Scholar]
- 21.Maidak, B. L., G. J. Olsen, N. Larsen, R. Overbeek, M. J. McCaughey, and C. R. Woese. 1997. The RDP (Ribosomal Database Project). Nucleic Acids Res. 25:109-111. [DOI] [PMC free article] [PubMed] [Google Scholar]
- 22.Odenyo, A. A., R. I. Mackie, D. A. Stahl, and B. A. White. 1994. The use of 16S rRNA-targeted oligonucleotide probes to study competition between ruminal fibrolytic bacteria: development of probes for Ruminococcus species and evidence for bacteriocin production. Appl. Environ. Microbiol. 60:3688-3696. [DOI] [PMC free article] [PubMed] [Google Scholar]
- 23.Piwonka, E. J., and J. L. Firkins. 1996. Effect of glucose fermentation on fiber digestion by ruminal microorganisms in vitro. J. Dairy Sci. 79:2196-2206. [DOI] [PubMed] [Google Scholar]
- 24.Russell, J. B., H. J. Strobel, and G. Chen. 1988. Enrichment and isolation of a ruminal bacterium with a very high specific activity of ammonia production. Appl. Environ. Microbiol. 54:872-877. [DOI] [PMC free article] [PubMed] [Google Scholar]
- 25.Rychlik, J. L., and J. B. Russell. 2000. Mathematical estimations of hyper-ammonia producing ruminal bacteria and evidence for bacterial antagonism that decreases ruminal ammonia production. FEMS Microbiol. Ecol. 32:121-128. [DOI] [PubMed] [Google Scholar]
- 26.Stackebrandt, E., H. Pohla, R. Kroppenstedt, H. Hippe, and C. R. Woese. 1985. 16S rRNA analysis of Sporomusa, Selenomonas, and Megasphaera: on the phylogenetic origin of Gram-positive eubacteria. Arch. Microbiol. 143:270-276. [Google Scholar]
- 27.Thompson, J. D., T. J. Gibson, F. Plewniak, F. Jeanmougin, and D. C. Higgins. 1997. The ClustalX Windows interface: flexible strategies for multiple sequence alignment aided by quality analysis tools. Nucleic Acids Res. 24:4876-4882. [DOI] [PMC free article] [PubMed] [Google Scholar]
- 28.Van Kessel, J. S., and J. B. Russell. 1992. The energetics of arginine and lysine transport by whole cells and membrane vesicles of strain SR, a monensin-sensitive ruminal bacterium. Appl. Environ. Microbiol. 58:969-975. [DOI] [PMC free article] [PubMed] [Google Scholar]
- 29.Wells, J. E., D. O. Krause, T. R. Callaway, and J. B. Russell. 1997. A bacteriocin-mediated antagonism by ruminal lactobacilli against Streptococcus bovis. FEMS Microbiol. Ecol. 22:237-243. [Google Scholar]
- 30.Yang, C. M. J., and J. B. Russell. 1993. The effect monensin supplementation on ruminal ammonia accumulation in vivo and the numbers of amino-acid fermenting bacteria. J. Anim. Sci. 71:3470-3476. [DOI] [PubMed] [Google Scholar]